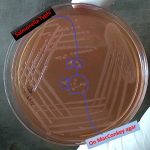
Salmonella on MacConkey agar
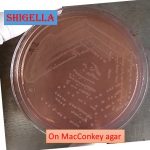
Shigella on MacConkey agar
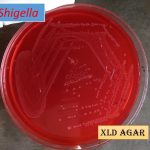

Collection Group: Clinical Bacteriology
Salmonella on MacConkey Agar and Its Pathogenecity, Laboratory Diagnosis and Treatment
Salmonella Typhi Growth of Salmonella Typhi on MacConkey agar is...
Salmonella Typhi Growth of Salmonella Typhi on MacConkey agar is...
Shigella on MacConkey agar: Introduction, Morphology, Culture Characteristics, Pathogenesis, Lab Diagnosis and Treatment
Shigella Shigella boydii colony characteristics on MacConkey agar are non-lactose fermenter colonies...
Shigella Shigella boydii colony characteristics on MacConkey agar are non-lactose fermenter colonies...
Shigella on XLD Agar: Introduction, Morphology, Culture Characteristics, Pathogenesis, Lab Diagnosis and Treatment
XLD agar with Shigella XLD stands for xylose lysine deoxycholate....
XLD agar with Shigella XLD stands for xylose lysine deoxycholate....
